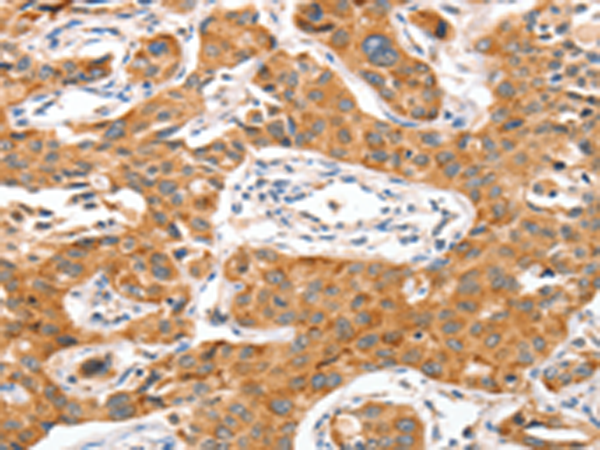

中文名稱: 兔抗NUAK1多克隆抗體
英文名稱: Anti-NUAK1 rabbit polyclonal antibody
別 名: ARK5
相關(guān)類別: 一抗
儲(chǔ) 存: 冷凍(-20℃)
宿 主: Rabbit
抗 原: NUAK1
反應(yīng)種屬: Human, Mouse
標(biāo) 記 物: Unconjugate
克隆類型: rabbit polyclonal
技術(shù)規(guī)格
|
Background: |
NUAK family SNF1-like kinase 1 also known as AMPK-related protein kinase 5 (ARK5) is an enzyme that in humans is encoded by the NUAK1 gene. Serine/threonine-protein kinase involved in various processes such as cell adhesion, regulation of cell ploidy and senescence, cell proliferation and tumor progression. Phosphorylates ATM, CASP6, LATS1, PPP1R12A and p53/TP53. Acts as a regulator of cellular senescence and cellular ploidy by mediating phosphorylation of 'Ser-464' of LATS1, thereby controlling its stability. Controls cell adhesion by regulating activity of the myosin protein phosphatase 1 (PP1) complex. Acts by mediating phosphorylation of PPP1R12A subunit of myosin PP1: phosphorylated PPP1R12A then interacts with 14-3-3, leading to reduced dephosphorylation of myosin MLC2 by myosin PP1. |
|
Applications: |
ELISA, IHC |
|
Name of antibody: |
NUAK1 |
|
Immunogen: |
Synthetic peptide of human NUAK1 |
|
Full name: |
NUAK family, SNF1-like kinase, 1 |
|
Synonyms: |
ARK5 |
|
SwissProt: |
O60285 |
|
ELISA Recommended dilution: |
2000-10000 |
|
IHC positive control: |
Human lung cancer and Human liver cancer |
|
IHC Recommend dilution: |
100-300 |
購物車
幫助
021-54845833/15800441009
